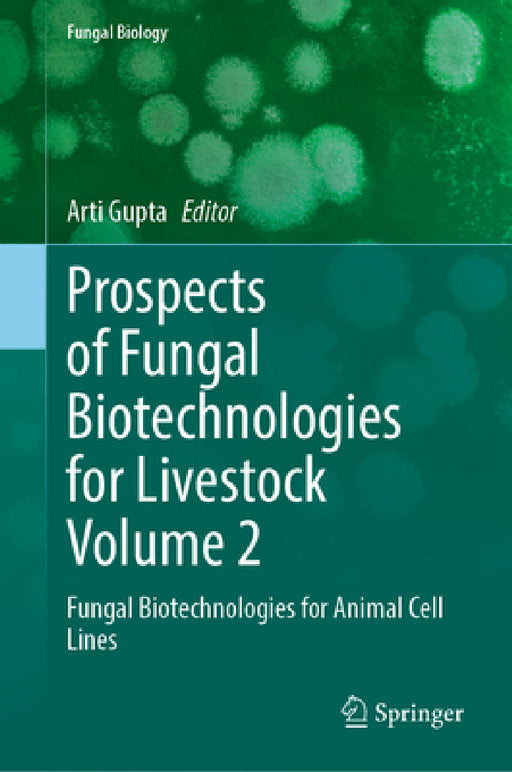
Prospects of Fungal Biotechnologies for Livestock Volume 2: Fungal Biotechnologies for Animal Cell Lines by Arti Gupta

Springer
Filters
Concrete and Circular Economy: Results of CCE 2025
Atef Daoud, György László Balázs
Hardcover
• Author(s): Atef Daoud | György László Balázs • Publisher: Springer • Publisher Imprint: Springer • BISAC: Civil - General
Helices
Angel Ferrandez Izquierdo
Hardcover
• Author(s): Angel Ferrandez Izquierdo • Publisher: Springer • Publisher Imprint: Springer • BISAC: Topology - GeneralThis book provides an overview of generalised helices, or Lancret helices, in both Riemannian and Lorentzian backgrounds. We wou...
View full detailsBehavioral Impact of Cannabinoids
Ziva D. Cooper, Sachin Patel, Stephen P. H. Alexander
Hardcover
• Author(s): Ziva D. Cooper | Sachin Patel | Stephen P. H. Alexander • Publisher: Springer • Publisher Imprint: Springer • BISAC: Life Sciences - NeuroscienceDespite millennia of proximity to, and consumption of products from, the Cannabis plant,...
View full detailsOperations Research and Management: Quantitative Methods for Planning and Decision-Making in Business and Economics
Franz W. Peren, Thomas Neifer
Hardcover
• Author(s): Franz W. Peren | Thomas Neifer • Publisher: Springer • Publisher Imprint: Springer • BISAC: Production & Operations Management
Employee Misfit: Theories, Perspectives, and New Directions
Jon Billsberry, Danielle L. Talbot
Hardcover
• Author(s): Jon Billsberry | Danielle L. Talbot • Publisher: Springer • Publisher Imprint: Springer • BISAC: Human Resources & Personnel Management
Navigating Through Crisis: Socio-Economic Impacts of Covid-19 in Mekong Region Countries
Sovannroeun Samreth, Netra Eng, Budy Prasetyo Resosudarmo
Hardcover
• Author(s): Sovannroeun Samreth | Netra Eng | Budy Prasetyo Resosudarmo • Publisher: Springer • Publisher Imprint: Springer • BISAC: Urban & RegionalThis open access book explores the socio-economic challenges and recovery efforts in Cambodi...
View full detailsSustainable Urban Future: Embracing Circular Economy in Waste Management
Sushobhan Majumdar, Moharana Choudhury, Ali Cheshmehzangi
Hardcover
• Author(s): Sushobhan Majumdar | Moharana Choudhury | Ali Cheshmehzangi • Publisher: Springer • Publisher Imprint: Springer • BISAC: Environmental Science (see also Chemistry - Environmental)
Ophthalmic Medical Image Analysis: 12th International Workshop, Omia 2025, Held in Conjunction with Miccai 2025, Daejeon, South Korea, September 27, 2
Huihui Fang, Meng Wang, Heng Li
Paperback
• Author(s): Huihui Fang | Meng Wang | Heng Li • Publisher: Springer • Publisher Imprint: Springer • BISAC: Artificial Intelligence - Computer Vision & Pattern RecognitThis book constitutes the refereed proceedings of the 12th International W...
View full detailsAlgebra Lineare
Marco Manetti
Paperback
• Author(s): Marco Manetti • Publisher: Springer • Publisher Imprint: Springer • BISAC: Algebra - LinearCi sono ottime ragioni per studiare algebra lineare; oltre ad essere da oltre un secolo una delle colonne portanti del metodo scientifico, con...
View full detailsCalculation of Seismic Actions for Structural Analysis: Methodological Approaches and Experiences
Enrico Zacchei, Reyolando M. L. R. F. Brasil
Paperback
• Author(s): Enrico Zacchei | Reyolando M. L. R. F. Brasil • Publisher: Springer • Publisher Imprint: Springer • BISAC: Civil - Soil & Rock
Numerical Methods for Metric Graphs: Eigenvalue Problems and Parabolic Partial Differential Equations
Anna Weller
Paperback
• Author(s): Anna Weller • Publisher: Springer • Publisher Imprint: Springer • BISAC: Differential Equations - General
Commissioning Management in Offshore Wind Projects: The Ultimate Guide
Christoph Hoppe
Paperback
• Author(s): Christoph Hoppe • Publisher: Springer • Publisher Imprint: Springer • BISAC: Power Resources - Alternative & RenewableThis book is a detailed exploration of commissioning management within the offshore wind industry, providing bo...
View full detailsEnergy-Management Integrated Circuit Design for Wireless Power and Data Transfer Applications
Byunghun Lee, Hyun-Su Lee, Junhyuck Lee
Hardcover
• Author(s): Byunghun Lee | Hyun-Su Lee | Junhyuck Lee • Publisher: Springer • Publisher Imprint: Springer • BISAC: Embedded Computer Systems
Proceedings of the International Conference on AI and Robotics: Air 2025, Volume 1
Jagdish Chand Bansal, Prashant Jamwal, Shahid Hussain
Paperback
• Author(s): Jagdish Chand Bansal | Prashant Jamwal | Shahid Hussain • Publisher: Springer • Publisher Imprint: Springer • BISAC: Artificial Intelligence - GeneralThis book gathers selected papers from International Conference on AI and Robotics ...
View full detailsThe Ph.D. Code: 60 Tips to Get Your Degree in Stem Subjects
Tomasz Liskiewicz, Grzegorz Liskiewicz
Hardcover
• Author(s): Tomasz Liskiewicz | Grzegorz Liskiewicz • Publisher: Springer • Publisher Imprint: Springer • BISAC: Study & TeachingThis book provides practical guidance and strategies for successfully completing a Ph.D. program. It covers a wi...
View full detailsPetroleum Geology
Hua Liu, Youlu Jiang
Hardcover
• Author(s): Hua Liu | Youlu Jiang • Publisher: Springer • Publisher Imprint: Springer • BISAC: Earth Sciences - GeologyBasic Characteristics of Oil, Natural Gas, and Oilfield Water.- Formation of Oil and Natural Gas.- Reservoirs and Cap Rocks.- ...
View full detailsChina's Railway Expansion in 40 Years of Economic Reform and Opening Up
Xueyong Zhang, Senlin Yu, Ruoyu Dai
Hardcover
• Author(s): Xueyong Zhang | Senlin Yu | Ruoyu Dai • Publisher: Springer • Publisher Imprint: Springer • BISAC: Asia - ChinaIntroduction.- 1.Initial Stage:Attempt to Eliminate Weak Links(1978-1985).- 2.Proactive Change:Overall Exploration of Refo...
View full detailsGenerative Ai, Contracts, Law and Design
Marcelo Corrales Compagnucci, Helena Haapio, Mark Fenwick
Hardcover
• Author(s): Marcelo Corrales Compagnucci | Helena Haapio | Mark Fenwick • Publisher: Springer • Publisher Imprint: Springer • BISAC: InternationalChapter 1 Generative AI and the Future of Contracts, Law and Design.- Chapter 2 No More Legal Writi...
View full detailsNatural Language Processing and Chinese Computing: 14th National Ccf Conference, Nlpcc 2025, Urumqi, China, August 7-9, 2025, Proceedings, Part II
Xian-Ling Mao, Zhaochun Ren, Muyun Yang
Paperback
• Author(s): Xian-Ling Mao | Zhaochun Ren | Muyun Yang • Publisher: Springer • Publisher Imprint: Springer • BISAC: Artificial Intelligence - GeneralThe four-volume set LNAI 16102 - 16105 constitutes the refereed proceedings of the 14th CCF Natio...
View full detailsICT Systems and Sustainability: Proceedings of Ict4sd 2025, Volume 6
Milan Tuba, Shyam Akashe, Amit Joshi
Paperback
• Author(s): Milan Tuba | Shyam Akashe | Amit Joshi • Publisher: Springer • Publisher Imprint: Springer • BISAC: Artificial Intelligence - GeneralThis book proposes new technologies and discusses future solutions for ICT design infrastructures, a...
View full detailsMaritime Transport and Supply Chain Resilience
Yui-Yip Lau, Adolf K. y. Ng, Zaili Yang
Hardcover
• Author(s): Yui-Yip Lau | Adolf K. y. Ng | Zaili Yang • Publisher: Springer • Publisher Imprint: Springer • BISAC: Production & Operations Management
Andean Herpetofauna: Explorations of Diversity, Ecology, and Conservation
J. Nicolás Urbina-Cardona, Carlos A. Navas, Alessandro Catenazzi
Hardcover
• Author(s): J. Nicolás Urbina-Cardona | Carlos A. Navas | Alessandro Catenazzi • Publisher: Springer • Publisher Imprint: Springer • BISAC: Environmental Conservation & Protection - GeneralThis book provides a multidisciplinary perspective o...
View full detailsWell-Being and Its Promotion in Educational Contexts: Global Perspectives and Local Challenges
Rubia Cobo-Rendón, Diego García-Álvarez, Alejandro Sánchez-Oñate
Hardcover
• Author(s): Rubia Cobo-Rendón | Diego García-Álvarez | Alejandro Sánchez-Oñate • Publisher: Springer • Publisher Imprint: Springer • BISAC: Educational Psychology
Natural Language Processing and Chinese Computing: 14th National Ccf Conference, Nlpcc 2025, Urumqi, China, August 7-9, 2025, Proceedings, Part I
Xian-Ling Mao, Zhaochun Ren, Muyun Yang
Paperback
• Author(s): Xian-Ling Mao | Zhaochun Ren | Muyun Yang • Publisher: Springer • Publisher Imprint: Springer • BISAC: Artificial Intelligence - GeneralThe four-volume set LNAI 16102 - 16105 constitutes the refereed proceedings of the 14th CCF Natio...
View full detailsGenedis 2024: Neuroscience and Neurodegenerative Disorders
Panagiotis Vlamos
Hardcover
• Author(s): Panagiotis Vlamos • Publisher: Springer • Publisher Imprint: Springer • BISAC: Life Sciences - NeuroscienceThe 6th Genomics, Neuroscience, Therapeutics, and Data Innovation Summit (GeNeDIS 2024) focuses on the latest major challenges...
View full detailsAn Anatomy of AI Surveillance in Africa: The Contradictions of Digital Technologies
Gorden Moyo
Hardcover
• Author(s): Gorden Moyo • Publisher: Springer • Publisher Imprint: Springer • BISAC: World - AfricanThis volume examines the use of artificial intelligence (AI) surveillance tools, such as closed-circuit television (CCTV), facial recognition, an...
View full detailsAdvances in Lean Manufacturing, Volume 2: Lean in Action: Solutions for Operational Excellence
Katarzyna Antosz, José Dinis Carvalho, José Carlos Vieira de Sá
Paperback
• Author(s): Katarzyna Antosz | José Dinis Carvalho | José Carlos Vieira de Sá • Publisher: Springer • Publisher Imprint: Springer • BISAC: Automation
Facing Vexing Problems for Community College Leaders: Perspectives and Guidance
Jon McNaughtan, Merrill Irving Jr, Terri L. Winfree
Hardcover
• Author(s): Jon McNaughtan | Merrill Irving Jr | Terri L. Winfree • Publisher: Springer • Publisher Imprint: Springer • BISAC: Schools - Levels - Higher
Prospects of Fungal Biotechnologies for Livestock Volume 2: Fungal Biotechnologies for Animal Cell Lines
Arti Gupta
Hardcover
• Author(s): Arti Gupta • Publisher: Springer • Publisher Imprint: Springer • BISAC: Life Sciences - MycologyThis multi-volume set encompasses a substantial amount of research on fungal infections, emphasising relevant data in the discussion. It ...
View full detailsEntrepreneurship in Southern Africa: How History Shaped the Present
Léo-Paul Dana, Aidin Salamzadeh
Hardcover
• Author(s): Léo-Paul Dana | Aidin Salamzadeh • Publisher: Springer • Publisher Imprint: Springer • BISAC: International - GeneralThis monograph explores the dynamic entrepreneurial landscapes of seven African nations--Botswana, Eswatini, Lesotho...
View full detailsInclusion in Education: Perspectives from Ghana
Dipane Hlalele, Awudu Salaam Mohammed
Hardcover
• Author(s): Dipane Hlalele | Awudu Salaam Mohammed • Publisher: Springer • Publisher Imprint: Springer • BISAC: Inclusive EducationThe book presents a practice-based conceptual analysis of enabling frameworks for inclusion in education within th...
View full detailsTheoretical Aspects of Computing - Ictac 2025: 22nd International Colloquium, Marrakech, Morocco, November 24-28, 2025, Proceedings
Zhiming Liu, Adnane Saoud, Heike Wehrheim
Paperback
• Author(s): Zhiming Liu | Adnane Saoud | Heike Wehrheim • Publisher: Springer • Publisher Imprint: Springer • BISAC: Computer ScienceThis book constitutes the proceedings of 22nd International Colloquium on Theoretical Aspects of Computing, ICTA...
View full detailsAI Enabled Robotic Loco-Manipulation: Proceedings of the Clawar 2025 Conference, Volume 2
Qiang Li, Ming Xie, Mohammad Osman Tokhi
Paperback
• Author(s): Qiang Li | Ming Xie | Mohammad Osman Tokhi • Publisher: Springer • Publisher Imprint: Springer • BISAC: Electrical
Rational Emotive Behavior Therapy: Foundations and Beyond
Windy Dryden
Paperback
• Author(s): Windy Dryden • Publisher: Springer • Publisher Imprint: Springer • BISAC: Psychotherapy - General
Mauritius and African Human Rights Law: A Critical Assessment of Challenges and Prospects
Roopanand Mahadew
Hardcover
• Author(s): Roopanand Mahadew • Publisher: Springer • Publisher Imprint: Springer • BISAC: Civil RightsThis book offers a comprehensive assessment of Mauritius's engagement with the African human rights system. Based on the premise that Mauritiu...
View full detailsWild Edibles and Sustainable Development Goals
Shalini Dhyani, Esther Katz
Hardcover
• Author(s): Shalini Dhyani | Esther Katz • Publisher: Springer • Publisher Imprint: Springer • BISAC: Food Science - General1. Wild edibles and their role in localizing UN SDGs.- 2. Traditional Ecological Knowledge and Gathering of Wild Mushroom...
View full detailsFuture Data and Security Engineering: 12th International Conference, Fdse 2025, Ho CHI Minh City, Vietnam, November 27-29, 2025, Proceedings, Part II
Tran Khanh Dang, Josef Küng, Tai M. Chung
Paperback
• Author(s): Tran Khanh Dang | Josef Küng | Tai M. Chung • Publisher: Springer • Publisher Imprint: Springer • BISAC: Artificial Intelligence - GeneralThis book constitutes the refereed proceedings of the 12th International Conference on Future D...
View full detailsDecolonizing Comparative Literature: Reading Across Southeast Asian Literatures
Chi P. Pham, Jose Monfred C. Sy, Thi Nhu Trang Nguyen
Hardcover
• Author(s): Chi P. Pham | Jose Monfred C. Sy | Thi Nhu Trang Nguyen • Publisher: Springer • Publisher Imprint: Springer • BISAC: Asian - GeneralThis book promotes a novel and nuanced understanding of how the practices of comparative literature h...
View full detailsLaw and Policy of the African Continental Free Trade Area (Afcfta): Prospects and Challenges for Trade and Investment in Africa
Tapiwa Victor Warikandwa, Howard Chitimira, Patrick C. Osode
Hardcover
• Author(s): Tapiwa Victor Warikandwa | Howard Chitimira | Patrick C. Osode • Publisher: Springer • Publisher Imprint: Springer • BISAC: International"The Africa We Want" has developed as a critical long-term development strategy for the African ...
View full detailsViral Diseases and One Health in Africa
Juliet Adamma Shenge, Akebe Luther King Abia
Hardcover
• Author(s): Juliet Adamma Shenge | Akebe Luther King Abia • Publisher: Springer • Publisher Imprint: Springer • BISAC: Sociology - GeneralViral diseases continue to be a public health threat to humans. Humanity has been affected over the years b...
View full detailsICT Systems and Sustainability: Proceedings of Ict4sd 2025, Volume 3
Milan Tuba, Shyam Akashe, Amit Joshi
Paperback
• Author(s): Milan Tuba | Shyam Akashe | Amit Joshi • Publisher: Springer • Publisher Imprint: Springer • BISAC: Artificial Intelligence - GeneralThis book proposes new technologies and discusses future solutions for ICT design infrastructures, a...
View full detailsArtificial Intelligence XLII: 45th Sgai International Conference on Artificial Intelligence, AI 2025, Cambridge, Uk, December 16-18, 2025, Proceedings
Max Bramer, Frederic Stahl
Paperback
• Author(s): Max Bramer | Frederic Stahl • Publisher: Springer • Publisher Imprint: Springer • BISAC: Artificial Intelligence - GeneralThis two-volume set, LNAI 16301 and LNAI 16302, constitutes the refereed proceedings of the 45th SGAI Internati...
View full detailsHigh Performance Computing: Isc High Performance 2025 International Workshops, Hamburg, Germany, June 10-13, 2025, Revised Selected Papers
Sarah Neuwirth, Arnab Kumar Paul, Tobias Weinzierl
Paperback
• Author(s): Sarah Neuwirth | Arnab Kumar Paul | Tobias Weinzierl • Publisher: Springer • Publisher Imprint: Springer • BISAC: Hardware - GeneralThis volume constitutes the revised selected papers of 40th International Conference on High Performa...
View full detailsThe Sexual Offences ACT 2003 and Virtual Reality: Applying Criminal Law in the Metaverse
Rhiannon Procktor
Paperback
• Author(s): Rhiannon Procktor • Publisher: Springer • Publisher Imprint: Springer • BISAC: InternationalThis book investigates online sexual interaction and its place within the law. Though this question is not new, the technological landscape i...
View full detailsCyber Security, Cryptology, and Machine Learning: 9th International Symposium, Cscml 2025, Be'er Sheva, Israel, December 4-5, 2025, Proceedings
Adi Akavia, Shlomi Dolev, Anna Lysyanskaya
Paperback
• Author(s): Adi Akavia | Shlomi Dolev | Anna Lysyanskaya • Publisher: Springer • Publisher Imprint: Springer • BISAC: Security - CryptographyThis volume constitutes the proceedings of 9th International Symposium on Cyber Security, Cryptology, an...
View full detailsThe Handbook of Loneliness
Todd Nelson
Hardcover
• Author(s): Todd Nelson • Publisher: Springer • Publisher Imprint: Springer • BISAC: Social Psychology
Advances in Practical Applications of Agents, Multi-Agent Systems, and Computational Social Science: The Paams Collection: 23rd International Conferen
Philippe Mathieu, Fernando de la Prieta
Paperback
• Author(s): Philippe Mathieu | Fernando de la Prieta • Publisher: Springer • Publisher Imprint: Springer • BISAC: Artificial Intelligence - GeneralThis book constitutes the refereed proceedings of the 23rd International Conference on Practical a...
View full detailsNano-Formulations for Sustainable Agriculture: Frontiers in Improving Crop Resilience to Abiotic Stressors
Chandra Shekhar Seth, Krishan K. Verma Ph. D., Faheem Ahmad
Hardcover
• Author(s): Chandra Shekhar Seth | Krishan K. Verma Ph. D. | Faheem Ahmad • Publisher: Springer • Publisher Imprint: Springer • BISAC: Agriculture - GeneralGlobal agricultural production faces various environmental stresses that affect crop grow...
View full detailsDie Eigentümlichkeit Des Weinkaufs: Über Die Sonderstellung Der Emptio Vini Im Römischen Vertragsrecht
Pia Friedrich
Paperback
• Author(s): Pia Friedrich • Publisher: Springer • Publisher Imprint: Springer • BISAC: Legal History
Artificial Intelligence XLII: 45th Sgai International Conference on Artificial Intelligence, AI 2025, Cambridge, Uk, December 16-18, 2025, Proceedings
Max Bramer, Frederic Stahl
Paperback
• Author(s): Max Bramer | Frederic Stahl • Publisher: Springer • Publisher Imprint: Springer • BISAC: Artificial Intelligence - GeneralThis two-volume set, LNAI 16301 and LNAI 16302, constitutes the refereed proceedings of the 45th SGAI Internati...
View full detailsData Science and Network Engineering: Proceedings of Icdsne 2025
Suyel Namasudra, Nirmalya Kar, Sarat Kumar Patra
Paperback
• Author(s): Suyel Namasudra | Nirmalya Kar | Sarat Kumar Patra • Publisher: Springer • Publisher Imprint: Springer • BISAC: Artificial Intelligence - GeneralThis book includes research papers presented at the International Conference on Data Sci...
View full detailsDocument Analysis and Recognition - Icdar 2025 Workshops: Wuhan, China, September 20-21, 2025, Proceedings, Part I
Lianwen Jin, Richard Zanibbi, Veronique Eglin
Paperback
• Author(s): Lianwen Jin | Richard Zanibbi | Veronique Eglin • Publisher: Springer • Publisher Imprint: Springer • BISAC: Artificial Intelligence - Computer Vision & Pattern RecognitThe two-volume set LNCS 16225 + 16226 constitutes the procee...
View full detailsSustainable Wealth Management Revisited: Female Leaders Transforming the Industry
Karen Wendt, Marta Ra
Hardcover
• Author(s): Karen Wendt | Marta Ra • Publisher: Springer • Publisher Imprint: Springer • BISAC: Industries - Financial Services
Density-Functional Theory for Electrons: Basic Theory and New Formalism
Hideaki Takahashi
Hardcover
• Author(s): Hideaki Takahashi • Publisher: Springer • Publisher Imprint: Springer • BISAC: Chemistry - Physical & TheoreticalIn this book, the author provides a detailed review and discussion on new density-functional theory (DFT) for electr...
View full detailsAdvances in Information and Computer Security: 20th International Workshop on Security, Iwsec 2025, Fukuoka, Japan, November 25-27, 2025, Proceedings
Carlos Cid, Naoto Yanai
Paperback
• Author(s): Carlos Cid | Naoto Yanai • Publisher: Springer • Publisher Imprint: Springer • BISAC: Security - GeneralThis book constitutes the proceedings of the 20th International Workshop on Security on Advances in Information and Computer Secu...
View full detailsData Science MBA: Big Data, Digitalization, and Strategy; With Applications in R
Alex Coad
Hardcover
• Author(s): Alex Coad • Publisher: Springer • Publisher Imprint: Springer • BISAC: Business & Productivity Software - Business IntelligenceThis text book focuses on what could be the most important challenge for firms to boost long-term prod...
View full detailsMulti-Modal Robotic Intelligence: An Active Perception Approach
Di Guo, Huaping Liu
Hardcover
• Author(s): Di Guo | Huaping Liu • Publisher: Springer • Publisher Imprint: Springer • BISAC: Robotics
Psilocybin Therapy
Gabriel Bennett
Paperback
• Author(s): Gabriel Bennett • Publisher: Springer • Publisher Imprint: Springer • BISAC: Clinical Psychology
AI 2025: Advances in Artificial Intelligence: 38th Australasian Joint Conference on Artificial Intelligence, AI 2025, Canberra, Act, Australia, Decemb
Miaomiao Liu, Xin Yu, Chang Xu
Paperback
• Author(s): Miaomiao Liu | Xin Yu | Chang Xu • Publisher: Springer • Publisher Imprint: Springer • BISAC: Networking - GeneralThis two-volume set LNAI 16370-16371 constitutes the refereed proceedings of the 38th Australasian Joint Conference on ...
View full detailsThree Times Emptiness: Śūnyatā, Kenosis, Fanā'
Thorsten Botz-Bornstein
Hardcover
• Author(s): Thorsten Botz-Bornstein • Publisher: Springer • Publisher Imprint: Springer • BISAC: ReligiousThis book offers a triangular comparative analysis by evaluating three different religious approaches to emptiness. It reveals what emptine...
View full details